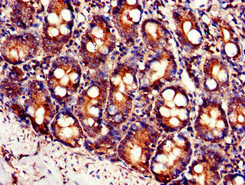
Immunohistochemistry of paraffin-embedded human small intestine tissue using CSB-PA849761LA01HU at dilution of 1:100

Western Blot Positive WB detected in: Mouse heart tissue All lanes: SLC7A6 antibody at 3ug/ml Secondary Goat polyclonal to rabbit IgG at 1/50000 dilution Predicted band size: 57 kDa Observed band size: 57 kDa
SLC7A6 Antibody
CSB-PA849761LA01HU
ApplicationsWestern Blot, ELISA, ImmunoHistoChemistry
Product group Antibodies
ReactivityHuman, Mouse
TargetSLC7A6
Overview
- SupplierCusabio
- Product NameSLC7A6 Antibody
- Delivery Days Customer20
- ApplicationsWestern Blot, ELISA, ImmunoHistoChemistry
- CertificationResearch Use Only
- ClonalityPolyclonal
- ConjugateUnconjugated
- Gene ID9057
- Target nameSLC7A6
- Target descriptionsolute carrier family 7 member 6
- Target synonymsLAT-2, LAT3, y+LAT-2, Y+L amino acid transporter 2, amino acid permease, cationic amino acid transporter, y+ system, solute carrier family 7 (amino acid transporter light chain, y+L system), member 6, solute carrier family 7 (cationic amino acid transporter, y+ system), member 6, y(+)L-type amino acid transporter 2, y+LAT2
- HostRabbit
- IsotypeIgG
- Protein IDQ92536
- Protein NameY+L amino acid transporter 2
- Scientific DescriptionInvolved in the sodium-independent uptake of dibasic amino acids and sodium-dependent uptake of some neutral amino acids. Requires coexpression with SLC3A2/4F2hc to mediate the uptake of arginine, leucine and glutamine. Also acts as an arginine/glutamine exchanger, following an antiport mechanism for amino acid transport, influencing arginine release in exchange for extracellular amino acids. Plays a role in nitric oxide synthesis in human umbilical vein endothelial cells (HUVECs) via transport of L-arginine. Involved in the transport of L-arginine in monocytes. Reduces uptake of ornithine in retinal pigment epithelial (RPE) cells.
- ReactivityHuman, Mouse
- Storage Instruction-20°C or -80°C
- UNSPSC41116161